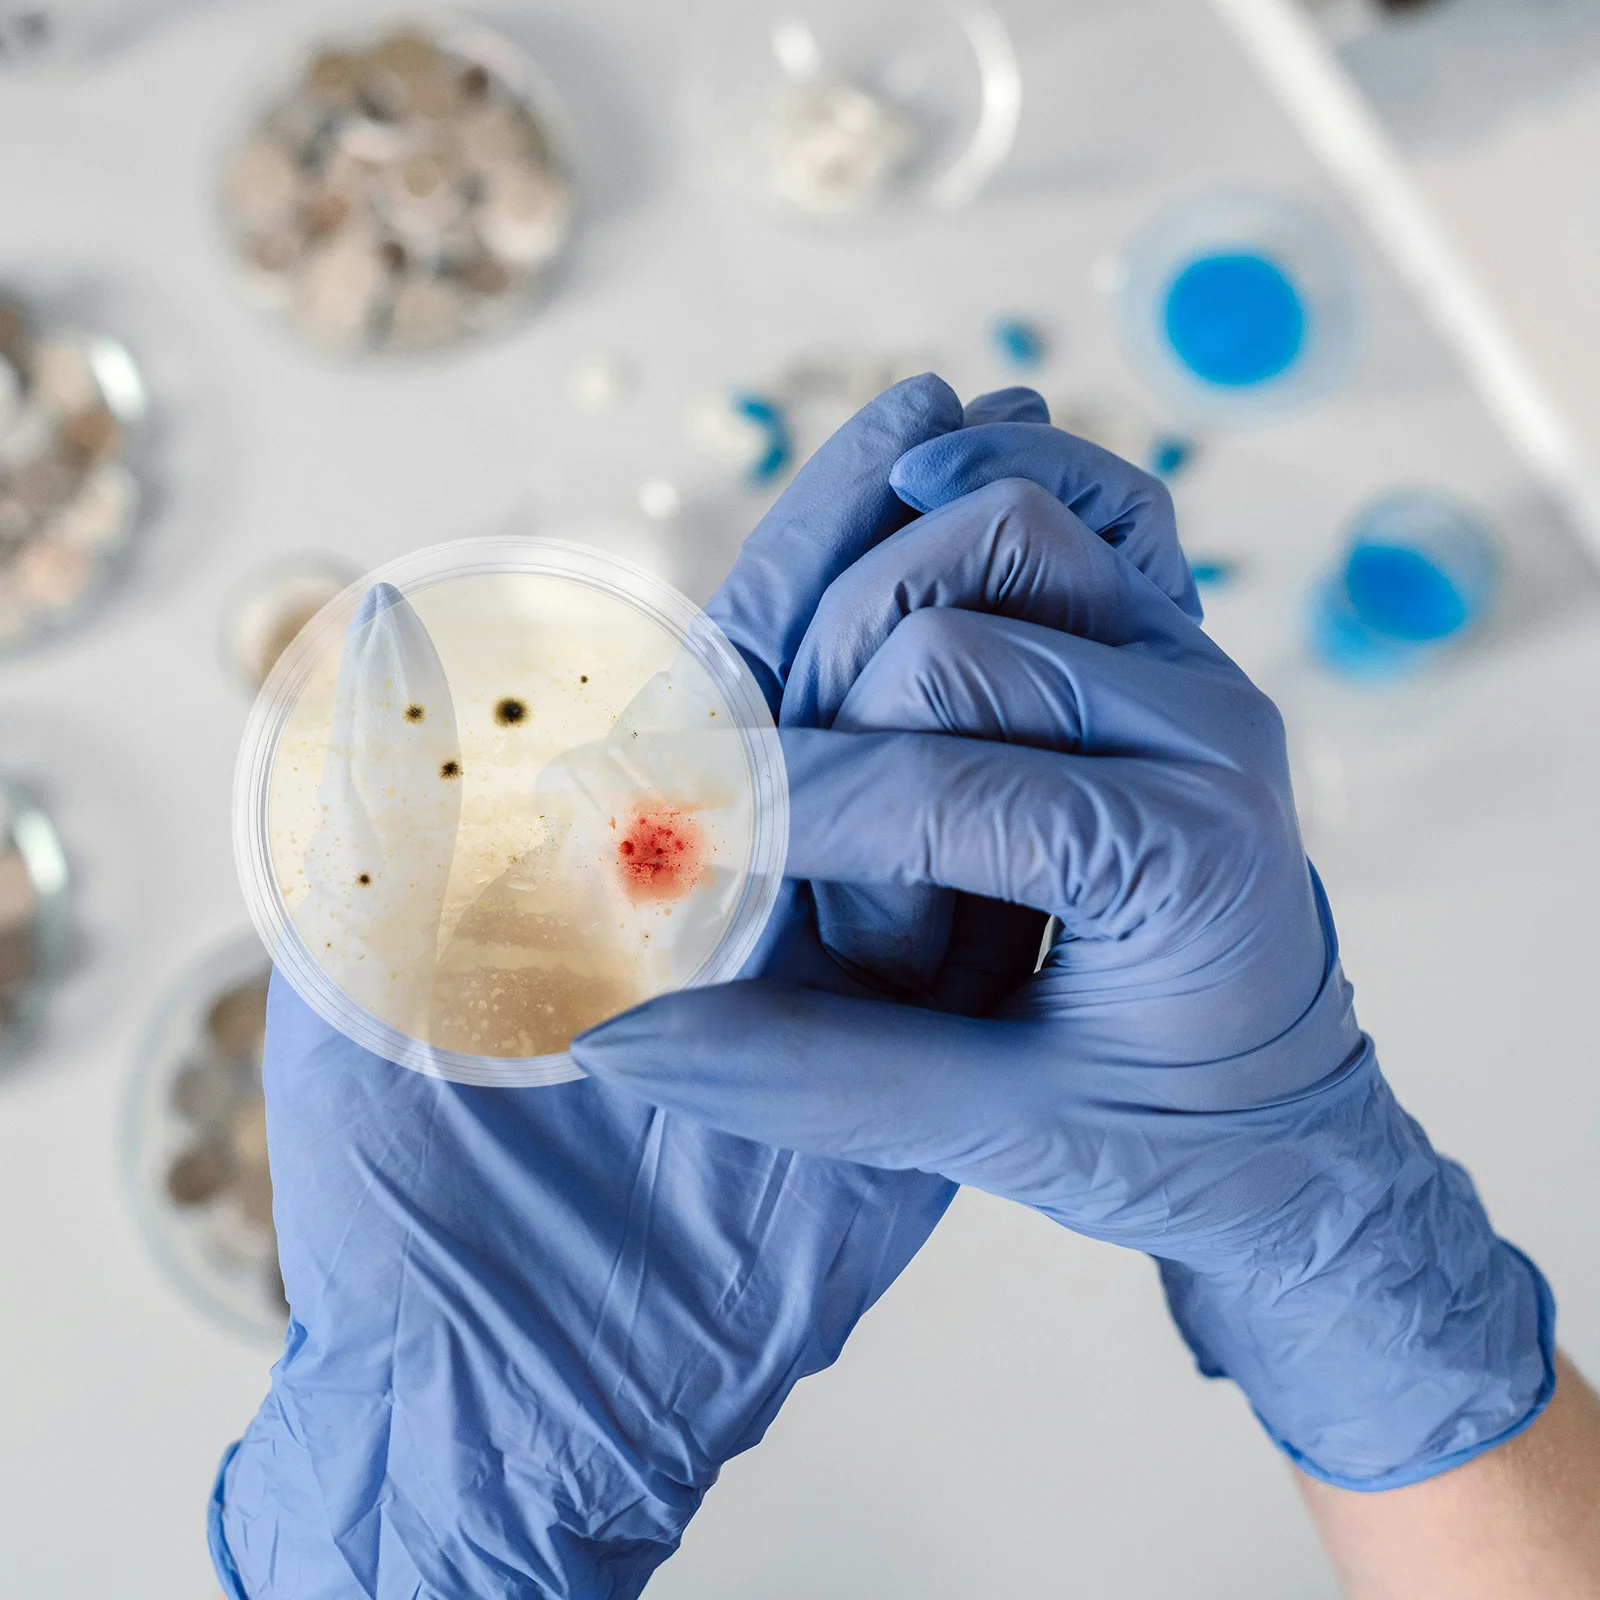
10Pcs 60Mm Laboratory Culture Dishes Clear Optical Flat Surface for Tissue Cell Observation Science Education Mycology Studies
10Pcs 60Mm Laboratory Culture Dishes Clear Optical Flat Surface for Tissue Cell Observation Science Education Mycology Studies

Kenzo three-button blazer - Brown
Description
three-button blazer from KENZO featuring beige, notched collar, long sleeves and front button placket.
Price history chart & currency exchange rate
Customers also viewed

$7.76
Мягкая кукла длиннорукая обезьяна плюшевые игрушки Мягкая кукла обезьяна банан обезьяна кукла плюшевая игрушка обезьяна синий
joom.ru
$175.21
2020 silver sequins bridesmaid dresses for wedding guest party one shoulder long sleeve plus size formal gowns for african b5842578, White;pink
dhgate.com
$71.24
2022 new fashion all-match ladies mini handbag summer small bag 2022 single shoulder msenger portable round
dhgate.com$18.41
Ретро код Замок записные книжки A5/B6 3-значный Замок 100 г без дерева бумажная обложка сменная книга для детей студент
banggood.com
$52.86
15cm anime nier automata figure yorha no. 9 type s pvc action figure collectible model toys kid gift
fordeal.com
$56.35
Ветровка GEJIAN, куртка, прямая Мужская куртка, военная форма, тактическая куртка, Мужская Водонепроницаемая дышащая тактическая куртка
aliexpress.com
$16.99
SONOFF WiFi Smart Light Switch Toughened Glass Panel T3UK3C-TX Touch Sensor Smart Wall Switch Voice Work with Alexa Google Home
aliexpress.com
$3.53
24PC Simple Leopard Print French False Nails Cat Eye Glossy Short Almond Press on Nails Full Cover Detachable Manicure Tips
aliexpress.com
$16.62
USB светодиодные книжные светильники 3 светодиода SMD светодиодная лампа 5 В Входная мощность Белый 5000-6500 К Теплый белый 3000-3500 К USB ночник внутреннее освещение
joom.ru
$10.42
1 рулон самоклеящейся пленки для окон с эффектом одуванчика, терморегулирующей защитой от ультрафиолета, непрозрачные наклейки на окна, специальная пленка для дверей и окон 4m
joom.ru
$961.23
Q181 New Chinese solid wood painted classical pine bedroom storage large wardrobe antique mortise and tenon decorative cabinet
aliexpress.com
$5.86
Trendy Vintage Denim Shoulder Bags Beggar Style Jeans Women's Tote Bag Versatile Plaid Commuting Bags Handbag
aliexpress.com
$2.57
ALIZERO 925 Sterling Silver Bracelet 6mm Side Chain Bracelets For Men Women Fashion Fine Jewelry Wholesale
aliexpress.com
$3.57
ADF Hinge Fit For Canon 1180 MF8280CW MF8330cdn D1380 LBP6140 350 D1350 1120 D530 1170 L190 1150 MF8250Cn MF8230Cn 729
aliexpress.com
$5.45
Wang Zijin Crown Theme Banner Photography Background Cloth, Children's Birthday Party Decoration Photography Studio Background
aliexpress.com
$28.81
Thermocouple thermometer YET-610/620L high precision digital thermometer probe thermometer
aliexpress.com
$2.14
50Pcs Miniature Landscape Trees Lifelike Simulated Banana Tree Models 7Cm for Train Scene Diorama and Home Scenery Decoration
aliexpress.com
$5.59
10pcs Rubber Valves Stem Snap-In Tubeless Replacement For Atv Motorbike Scooter Wheel Valves Stem Motorcycle Accessories Wear
aliexpress.com
$4.62
Nylon Elastic Strap + Case For Xiaomi Mi Band 3/4/5/6/7/8/9 Quick Release Hard-wearing Replacement Wristband Watch Accessories
aliexpress.com
$79.60
For GMW haval h6 Accessories 2024 Carbon look Garnish Car Door Sill Scuff Plate Welcome Pedal Protection Trim 4pcs
aliexpress.com
$14.61
Women's Spring/Summer Floral Dress Black Base Colorful Flower Pattern Versatile Stylish Pick Outings
aliexpress.com
$72.50
36V 10400mAh 10S4P Electric Scooter Lithium Battery Pack 18650 Cells with BMS for 750W-1000W Scooters
aliexpress.com
$8.24
Wooden Case With Grid Removable Pillows Storage For Display Jewelry Organizer Gift Package Watch Box For Storage Watch Display
aliexpress.com
$467.34
CL sense real restaurant cupboard household kitchen kitchenette cabinet locker storage cupboard
aliexpress.com
$3.92
1pc Women'S Lace Hat Cotton Floral Design Adjustable For Spring Summer Daily Party Travel Photo Prop Lace Hat
aliexpress.com
$16.00
Car Stabilizer Link For Suzuki Vitara 201501 - 1.4T 1.6L Swift SX4 Liana Fabia Rapid Spaceback Jetta Santana Lavida Polo Part
aliexpress.com
$6.53
Bridal Pearl Crown Tiara Flower Rhinestone Crystal Necklace Earrings Wedding Jewelry Set Elegant Lightweight for Wedding
aliexpress.com
$92.60
camping chairOversized Portable Camping Chair Heavy Duty Folding Chair 400 LBS Capacity Padded Seat Outdoor Lightweight Lawn
aliexpress.com
$24.21
10Pcs 60Mm Laboratory Culture Dishes Clear Optical Flat Surface for Tissue Cell Observation Science Education Mycology Studies
aliexpress.com
$706.98
Reborn 200T LED Replacement Module for Source Four Profile Spotlights for Conference Live Broadcast Studio Museum Theatre
aliexpress.com
$676.92
STLF High Quality 1600W DIY Industrial Grade Lawn Mower 20V Lithium Battery High Quality Grass Cutting Machine for Garden Use
aliexpress.com
$20.16
High Quality New EB-BG980ABY Mobile Phone Battery 3.86V 3880mAh For Samsung S20 5G Replacement Battery
aliexpress.com
$2.35
2pcs High Heel Flowers Detachable Flower Shoe Clips Elegant Floral Decoration Diy Shoe Accessories Women Shoes Collar Flowers
aliexpress.com










